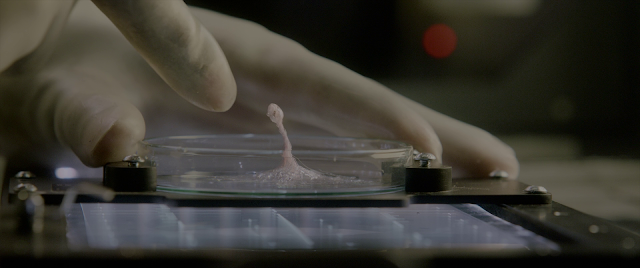

Seis miembros de la tripulación de la Estación Espacial Internacional están a punto de lograr uno de los descubrimientos más importantes en la historia humana: la primera evidencia de vida extraterrestre en Marte. A medida que el equipo comienza a investigar y sus métodos tienen consecuencias inesperadas, la forma viviente demostrará ser más inteligente de lo que cualquiera esperaba.
Mas Info:
Life es una película estadounidense de ciencia ficción y suspense dirigida por Daniel Espinosa y escrita por Paul Wernick y Rhett Reese. Es protagonizada por Jake Gyllenhaal, Rebecca Ferguson, Ryan Reynolds y Hiroyuki Sanada. Fue estrenado el 24 de marzo de 2017 por Columbia Pictures.
Life (2017)
BDRIP | MKV | Resolución 1920×804p| Idiomas: Español Latino AC3 5.1
Ingles DTS-HD MA 7.1 | Subtitulos: Español Latino, | Ciencia Ficción| 12 GB

Subido por: Freaked
Subido por: Freaked



















